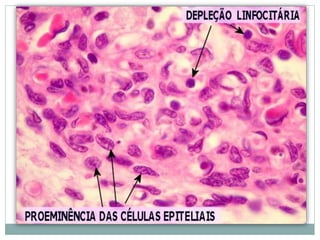

O documento discute a imunossenescência, que é o envelhecimento do sistema imune. Apresenta as principais alterações funcionais e morfológicas nas células do sistema imune com a idade, como a involução tímica e deficiências nutricionais. Também aborda a menor eficácia das vacinas em idosos e perspectivas futuras para melhorar a função imune no envelhecimento.